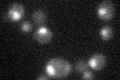
YBR231C
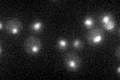
YBR231C

View description
Protein of unknown function, component of the SWR1 complex, which exchanges histone variant H2AZ (Htz1p) for chromatin-bound histone H2A
Localization:
Intensity:
Fold change:
Significance:
-
C’ GFP library in SD

nucleus25.82 -
N' NOP1pr-GFP in SD

nucleus40.6643 -
N' TEF2pr-mCherry in SD

nucleus15.9979 -
N' NATIVEpr-GFP in SD

nucleus23.5852 -
N' TEF2pr-VC and Cyto-VN in SD

nucleus29.8825 -
C’ GFP library in SD+DTT

nucleus27.691.07No -
C’ GFP library in SD+H2O2
nucleus28.021.08No -
C’ GFP library in Starvation Media
nucleus28.41.1No -
C’ GFP library on the background of Pup2-DaMP

nucleus -
C’ GFP library on the background of CCT mutant

nucleus27.33311.05845No
